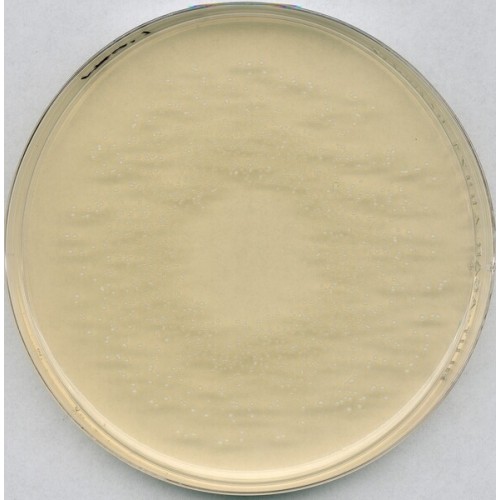

ROGOSA AGAR(LACTOBACILLUS SELECTIVE AGAR) MERCK - EMB 500G
Modelo: 1054130500
-
R$915,46
ou até 3x de R$305,15 sem juros
Economize 5% no PIX: R$869,69
ou 3.5% no boleto: R$883,42
Descrição
ROGOSA AGAR (LACTOBACILLUS SELECTIVE AGAR) MERCK
RENDIMENTO 74,5g/l
Embalagem 500g.
Mode of Action
The accompanying bacterial flora is largely suppressed by the high acetate concentration and the low pH value. Low concentrations of manganese, magnesium and iron ensure optimal growth of lactobacilli.
Typical Composition (g/litre)
Peptone from casein 10.0;
yeast extract 5.0;
D(+)glucose 20.0;
potassium dihydrogen phosphate 6.0;
ammonium citrate 2.0;
Tween® 80 1.0;
sodium acetate 15.0;
magnesium sulfate 0.575;
iron(II) sulfate 0.034;
manganese sulfate 0.12;
agar-agar 15.0.
Preparation
Suspend 74.5 g/litre, adjust the pH to 5.5 with acetic acid 96 % (approx. 1.3 ml/litre).
Do not autoclave.
pH: 5.5 ± 0.2 at 25 °C.
The plates are clear and yellowish-brown.
RENDIMENTO 74,5g/l
Embalagem 500g.
Mode of Action
The accompanying bacterial flora is largely suppressed by the high acetate concentration and the low pH value. Low concentrations of manganese, magnesium and iron ensure optimal growth of lactobacilli.
Typical Composition (g/litre)
Peptone from casein 10.0;
yeast extract 5.0;
D(+)glucose 20.0;
potassium dihydrogen phosphate 6.0;
ammonium citrate 2.0;
Tween® 80 1.0;
sodium acetate 15.0;
magnesium sulfate 0.575;
iron(II) sulfate 0.034;
manganese sulfate 0.12;
agar-agar 15.0.
Preparation
Suspend 74.5 g/litre, adjust the pH to 5.5 with acetic acid 96 % (approx. 1.3 ml/litre).
Do not autoclave.
pH: 5.5 ± 0.2 at 25 °C.
The plates are clear and yellowish-brown.